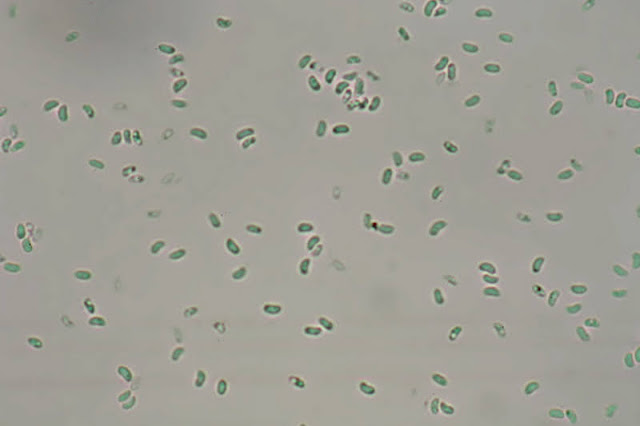

Yesquero de tocones y troncos muertos de diversas especies de caducifolios en forma de concha o abanico, semicirculares, con superficie muy débilmente afelpada, casi lisa y sin pelos, sin bandas concéntricas o solo con una o dos bandas diferenciadas por el color que es blanco y poros redondeados a angulosos, muy pequeños. VER DESCRIPCIÓN COMPLETA.
Superficie del carpóforo muy débilmente afelpada, casi lisa y sin pelos hirsutos, sin bandas concéntricas o solo con una o dos bandas diferenciadas por el color que es blanco, crema a ocráceo con margen agudo, sinuoso, a veces desgarrado e irregular.
Sección transversal de la capa superficial del sombrero donde se aprecia una estructura muy homogénea y compacta sin apenas diferenciación de la superficie (parte baja de la foto)
Cutícula indiferenciada del resto de la carne o trama, solo con terminaciones de hifas erectas que dan lugar a una superficie afelpada, pero no hirsuta.
Terminaciones de hifas esqueléticas erectas que tapizan la superficie del sombrero.
Por debajo la superficie presenta una coloración blanca, crema y hasta ocre en los viejos ejemplares y formada por poros redondeados a angulosos, muy pequeños, 3 a 5 por milímetro.
En sección transversal se aprecia que el himenio son perforaciones que se introducen dentro de la trama hasta aproximadamente 1cm.
La carne o trama del carpóforo es de tipo dimítica, es decir formada por dos tipos de hifas, esqueléticas y generativas.
Desgarrando una pequeña porción de la carne o trama vemos que la mayor parte son hifas esqueléticas muy gruesas y fuertemente entrelazadas.
Las hifas esqueléticas presentan paredes muy gruesas, son muy poco ramificadas y carecen de tabiques.
De manera más dispersa y escasa hifas esqueléticas un poco retorcidas y ramificadas entrelazan las hifas esqueléticas dando lugar a una carne un poco más coriácea y resistente al desgarro.
En los bordes de los poros las hifas esqueléticas terminan en forma de pelos que facilitan la dispersión de las esporas.
En todo el interior de los orificios del himenio se producen grandes cantidades de diminutas esporas, incoloras al microscopia pero blancas en masa.